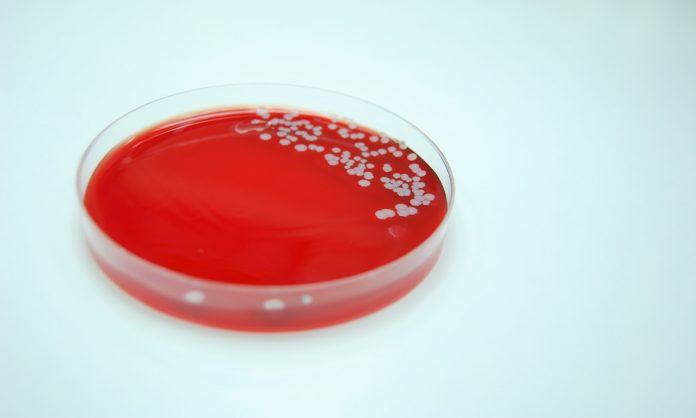
Bacterial Culture of Staphylococcus aureus

A study has found a pharmacy-driven protocol using nasal swabs to assess methicillin‑resistant Staphylococcus aureus (MRSA) in pneumonia cases holds promise for reducing unnecessary use of vancomycin, recommended when there is a high risk of MRSA infection.
Researchers at a US hospital evaluated the effectiveness of use of the nasal swab MRSA polymerase chain reaction (PCR) test to discontinue vancomycin on the duration of vancomycin therapy and clinical outcomes in patients with suspected community-acquired pneumonia (CAP) or healthcare-associated pneumonia (HCAP).
US and Australian guidelines call for patients with suspected pneumonia to be initiated on broad-spectrum empiric antibiotics for certain patient groups, including anti-MRSA therapy.
‘However, it is often difficult to obtain a good-quality lower respiratory tract specimen for culture, leaving physicians with poor quality specimens or no culture data at all. For this reason, physicians are often reluctant to remove antibiotics directed toward MRSA,’ the St Mary’s Medical Center researchers wrote.¹
The nasal swab MRSA PCR test has gained interest as a rapid diagnostic tool for MRSA, able to return results in as little as 90 minutes², but it has traditionally been used as a tool to reduce the transmission of MRSA.³
For the study, the nasal swab MRSA PCR test was added as an automatic order to the CAP/HCAP order set in patients with suspected CAP or HCAP. If the results were negative and there was no apparent MRSA infection elsewhere, the pharmacist was permitted to discontinue vancomycin treatment without a physician’s order.
Of the 196 patients included in the study, the 121 patients in the pre-intervention group received CAP/HCAP order set without nasal swab MRSA PCR test; whereas the 75 patients in the post-intervention group received the additional nasal swab MRSA PCR test to the CAP/HCAP order set.¹
The median duration of vancomycin therapy was significantly shorter in the post-intervention group than the pre-intervention group, at 49 hours compared to 18 hours, however there were no statistically significant differences in the secondary outcomes, including hospital length of stay, 30-day re-admission rate, and in-hospital all-cause mortality.
The researchers concluded:
‘The results of this study provide additional evidence that the nasal swab MRSA PCR test may be a useful antimicrobial stewardship tool to guide discontinuation of empiric anti-MRSA therapy in patients with suspected CAP or HCAP, particularly when adequate lower respiratory tract cultures are not available. The addition of a pharmacy-driven protocol utilising the nasal swab MRSA PCR test was associated with a shorter duration of empiric vancomycin therapy by approximately 31 h (hours) per patient without increasing adverse clinical outcomes. Further studies are needed to confirm these results.’
Read the full article here.
References:
- Dunaway, S., Orwig, K.W., Arbogast, Z.Q. et al. Int J Clin Pharm (2018) 40: 526. https://doi.org/10.1007/s11096-018-0647-3
- Smith EA, Gold HS, Mahoney MV, et al. Nasal methicillin-resistant Staphylococcus aureus screening in patients with pneumonia: a powerful antimicrobial stewardship tool. Am J Infect Control. 2017;17(11):1295–1296.
- Huang SS, Yokoe DS, Hinrichsen VL, Spurchise LS, Datta R, Miroshnik I, et al. Impact of routine intensive care unit surveillance cultures and resultant barrier precautions on hospital-wide methicillin-resistant Staphylococcus aureus bacteremia. Clin Infect Dis. 2006;43(8):971–8.